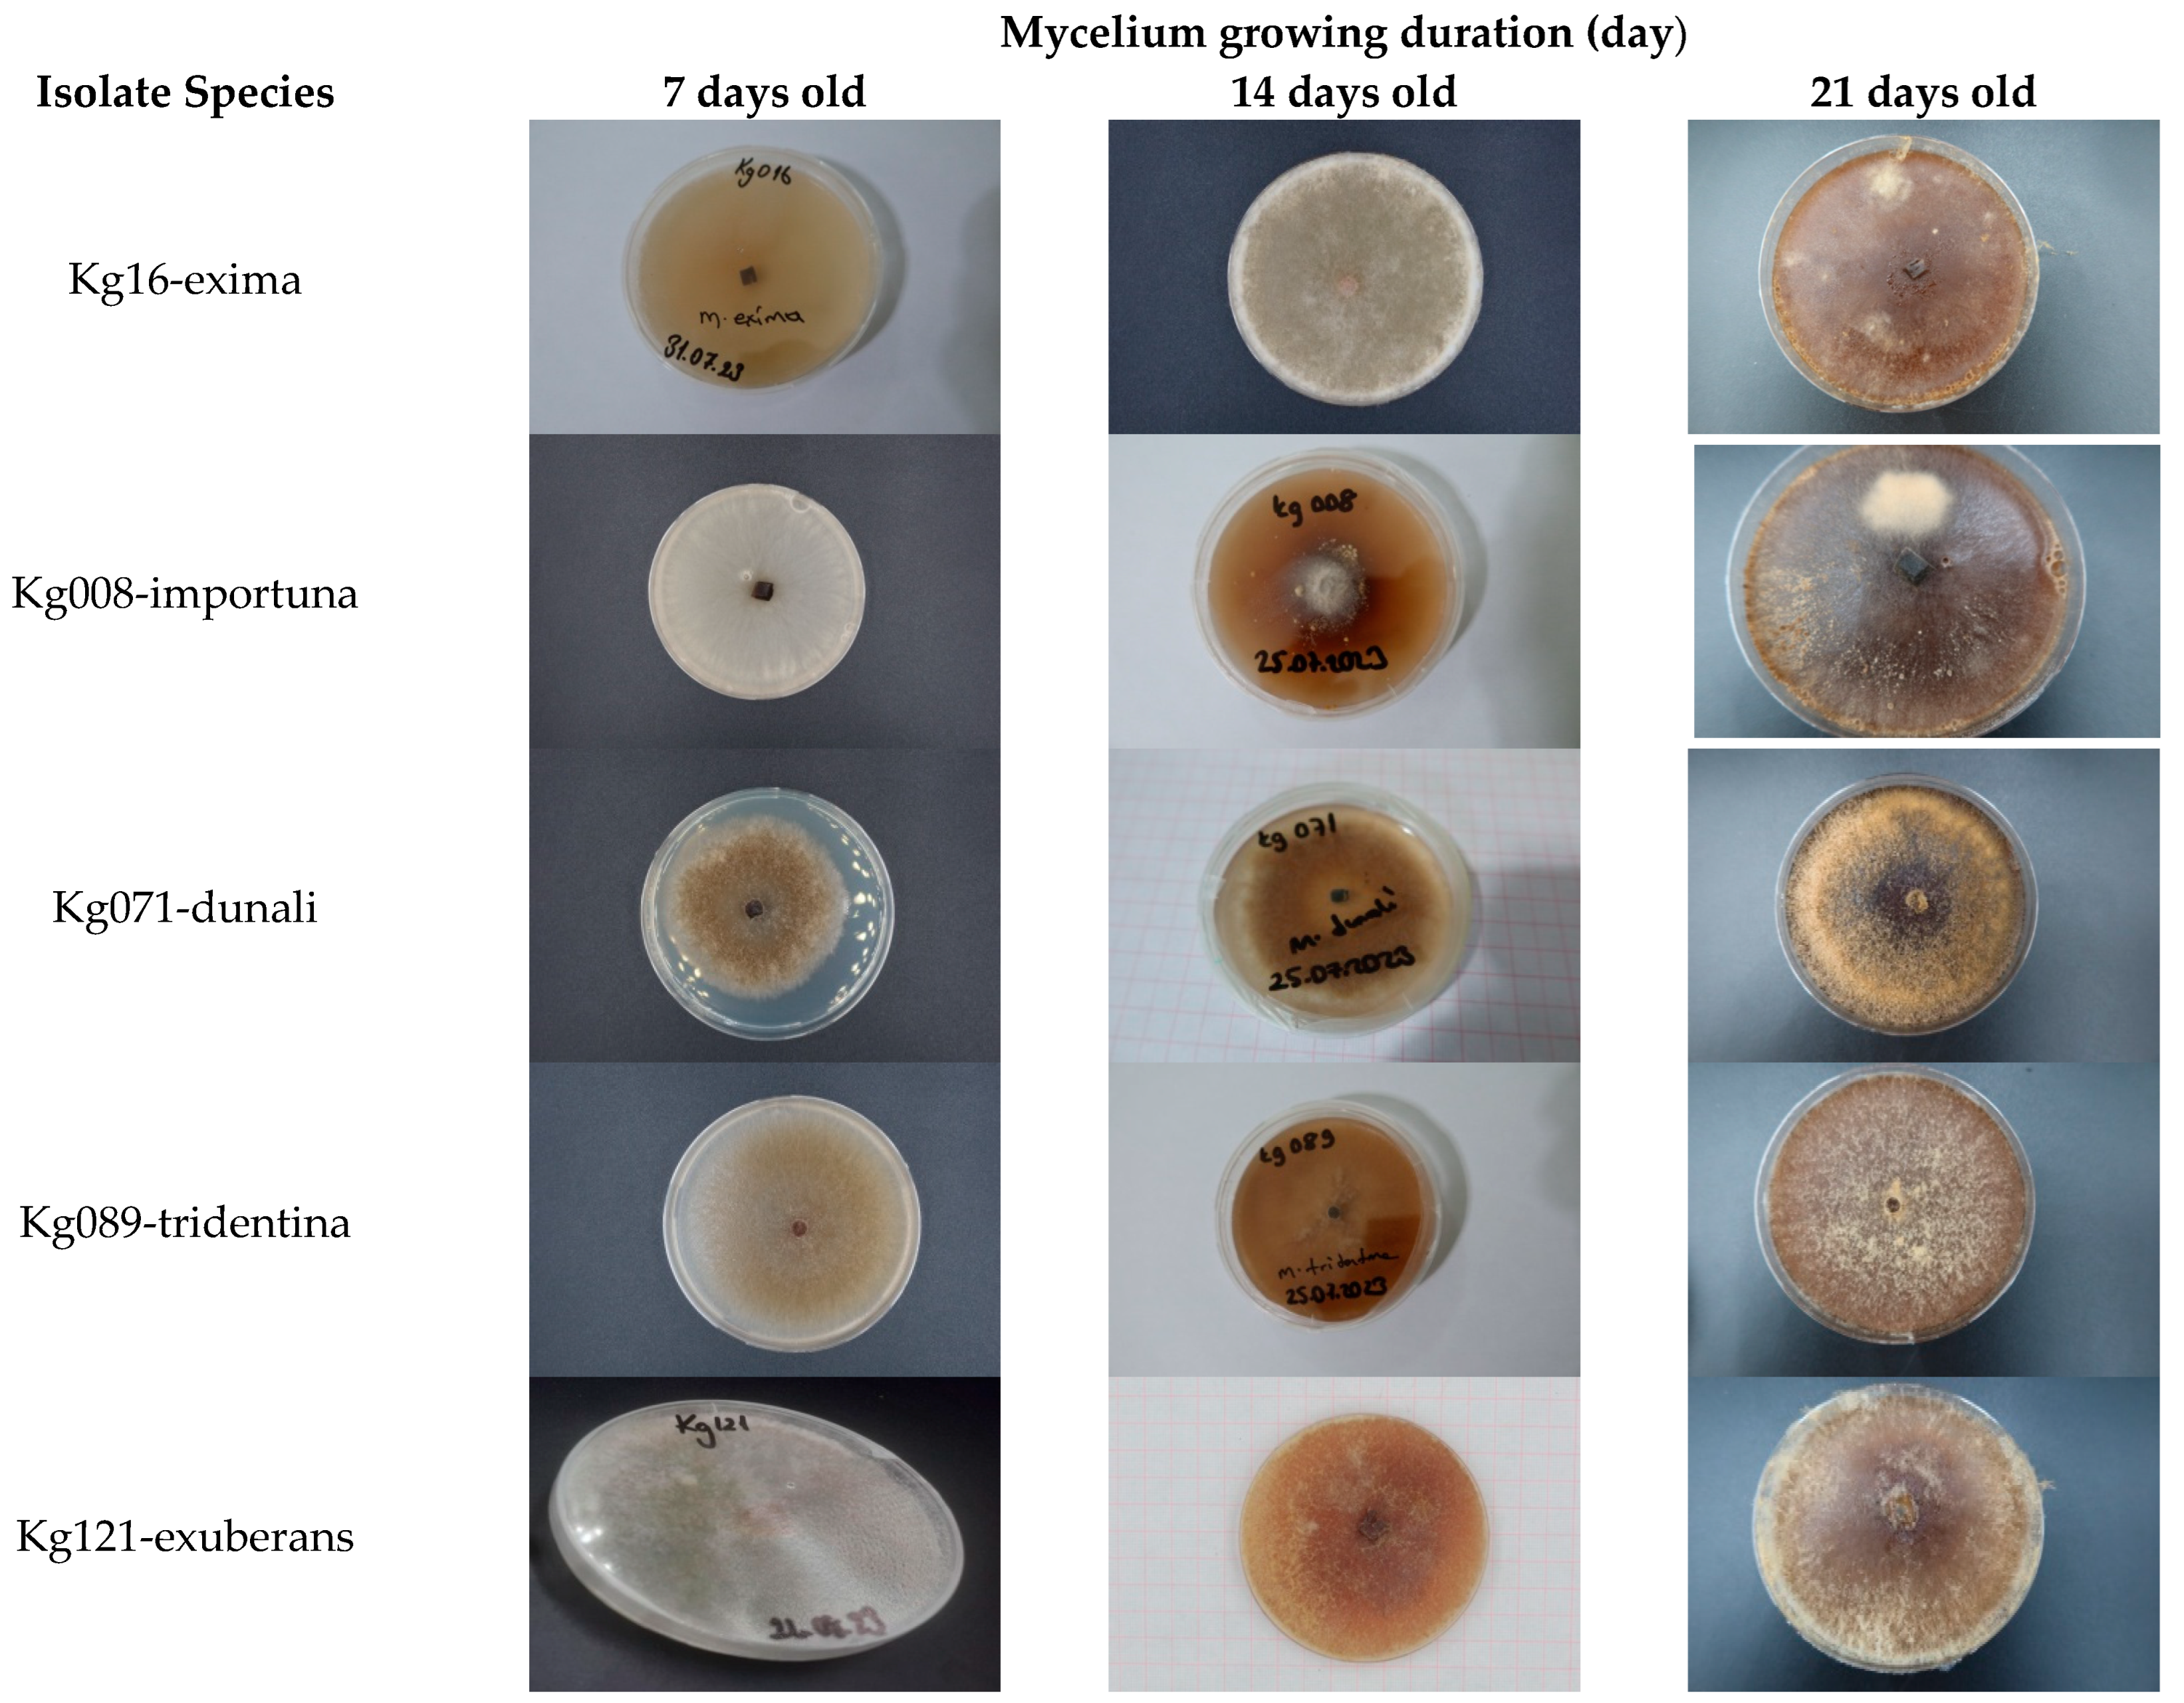
Horticulturae 10 01020 g003a
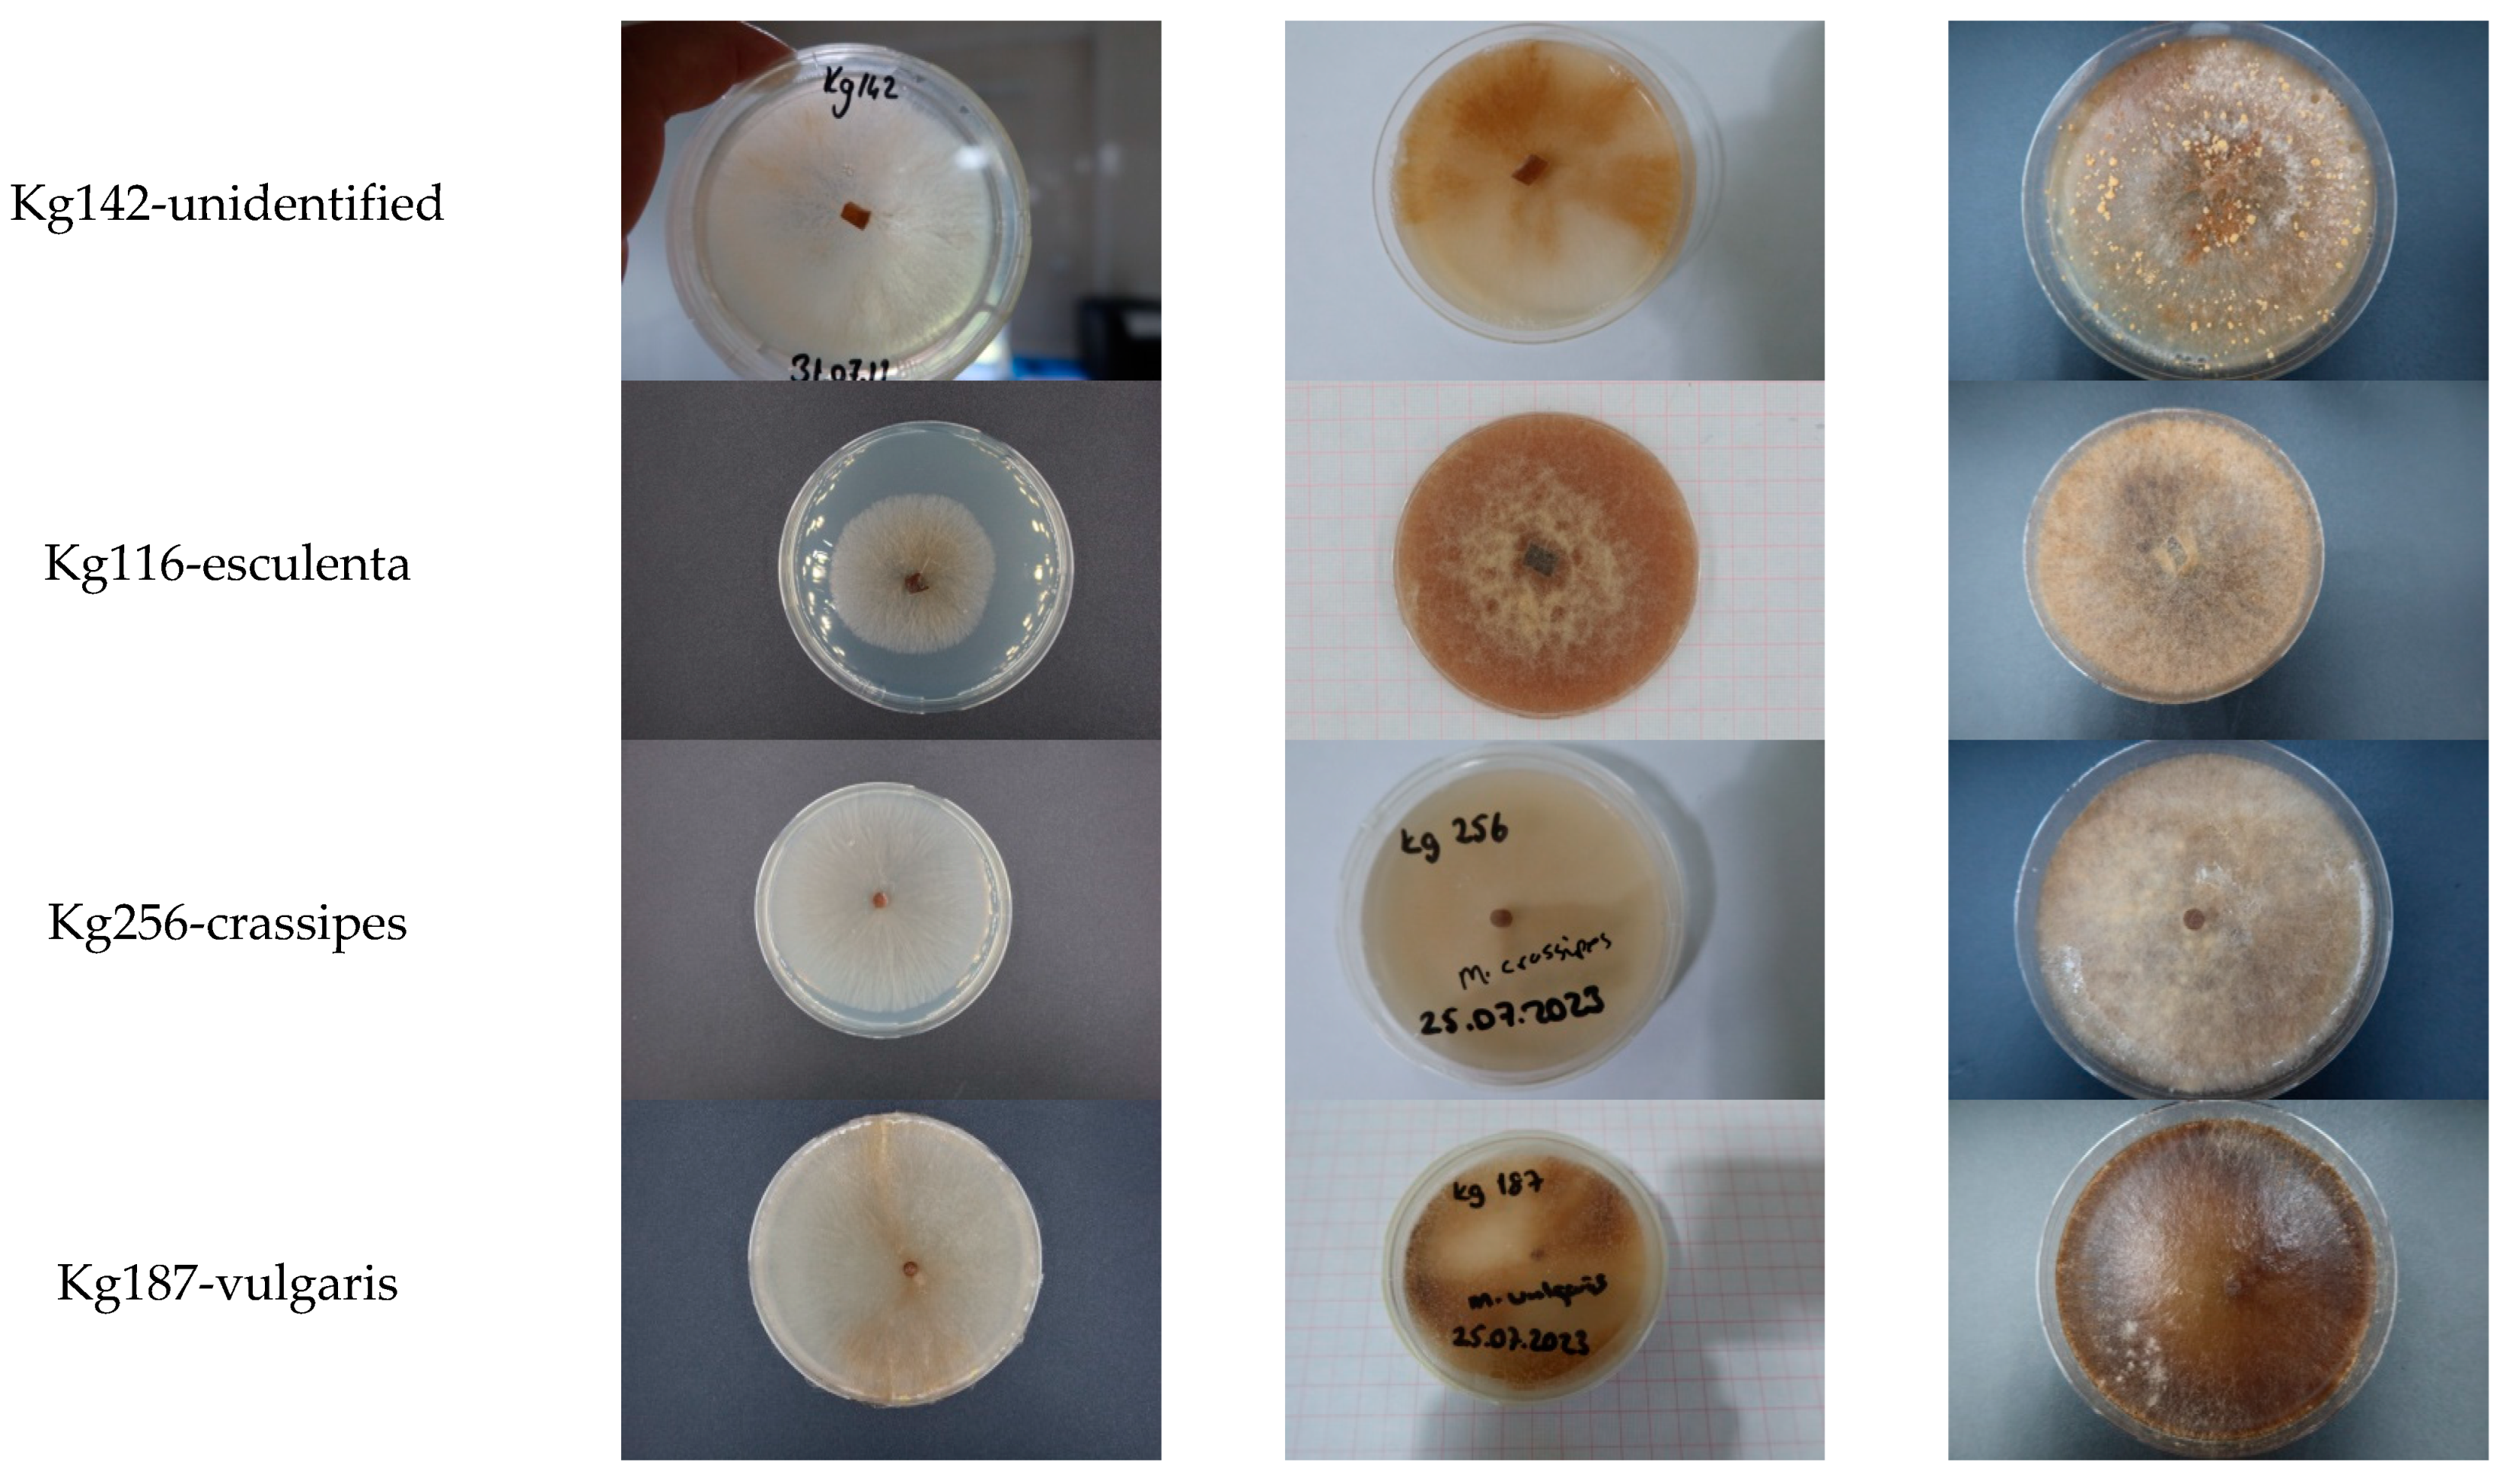
Horticulturae 10 01020 g003b

Isolation and Molecular Identification of the Pure Culture of Morchella Collected from Türkiye and Its Characteristics
Abstract
1. Introduction
2. Material and Methods
2.1. Collection of the Specimens
2.2. Isolation the Cultures
2.3. DNA Extraction of the Cultures
2.4. PCR Amplification and Sequencing
2.5. Phylogenetic Relationship Analysis
2.6. Culture Characteristics and Colony Morphology
3. Results
3.1. Collection of the Specimens and Isolation of the Cultures
3.2. Molecular Identification of Morchella Isolates
- M. crassipes: K115-GBK962, Kg250-1012, Kg106-956, Kg176-972, Kg254-1013, Kg257-1014
- M. esculenta: GBK961-Kg116, M10110
- M. vulgaris: GBK976, which showed maximum similarity with M. vulgaris and the M. spongiola clade
- M. tridentina (formerly M. frustrata): 848-Kg137, Kg088-951, Kg089-955, Kg108-957, Kg136-965, Kg146-967, Kg178-974
- M. exuberans: K121-GBK963
- M. eximia: GBK851-Kg016, 855-Kg001, 856, 969-Kg161, 1017-Kg266
- M. importuna: GBK845-Kg019, 846-Kg010, 852-Kg008, 949-Kg030, 952-Kg0140, 964-Kg133, 968-Kg152, 970-Kg164, 971-Kg167, 973-Kg177, 975-Kg181, 977, 978-Kg189
- M. dunali: GBK953-Kg054, 954-Kg71
- GBK849-Kg027 and 966-Kg142 could not be clearly identified but were closely related to M. laurentiana, M. eohespera, and M. purperescens clades.
3.3. Macro-Morphologic Characters, Habitat, and Distribution
3.4. Cultural Characters of the Morchella
4. Discussion
5. Conclusions
Funding
Data Availability Statement
Acknowledgments
Conflicts of Interest
References
- Hibbett, D.S.; Binder, M.; Bischoff, J.F.; Blackwell, M.; Cannon, P.F.; Eriksson, O.E.; Huhndorf, S.; James, T.; Kirk, P.M.; Lücking, R.; et al. A higher-level phylogenetic classification of the fungi. Mycol. Res. 2007, 111, 509–547. [Google Scholar] [CrossRef] [PubMed]
- Sa, W.; Qiao, J.; Gao, Q.; Li, Z.; Shang, Q. DNA Barcoding and Species Classification of Morchella. Genes 2022, 13, 1806. [Google Scholar] [CrossRef]
- Li, Y.; Chen, H.; Zhang, X. Cultivation, nutritional value, bioactive compounds of morels, and their health benefits: A systematic review. Front. Nutr. 2023, 10, 1159029. [Google Scholar] [CrossRef] [PubMed] [PubMed Central]
- Magrati, T.P.; Tripathee, H.P.; Devkota, K.P. Nutritional Analysis of Morchella conica and its Role on Rural Livelihood. Nepal J. Sci. Technol. 2011, 12, 119–126. [Google Scholar] [CrossRef]
- Beluhan, S.; Ranogajec, A. Chemical composition and non-volatile components of Croatian wild edible mushrooms. Food Chem. 2011, 124, 1076–1082. [Google Scholar] [CrossRef]
- Heleno, S.A.; Stojković, D.; Barros, L.; Glamočlija, J.; Soković, M.; Martins, A.; Queiroz, M.J.R.; Ferreira, I.C. A comparative study of chemical composition, antioxidant and antimicrobial properties of Morchella esculenta (L.) Pers. from Portugal and Serbia. Food Res. Int. 2013, 51, 236–243. [Google Scholar] [CrossRef]
- Vieira, V.; Fernandes, Â.; Barros, L.; Glamočlija, J.; Ćirić, A.; Stojković, D.; Martins, A.; Soković, M.; Ferreira, I.C. Wild Morchella conica Pers. from different origins: A comparative study of nutritional and bioactive properties. J. Sci. Food Agric. 2016, 96, 90–98. [Google Scholar] [CrossRef]
- Altaf, U.; Lalotra, P.; Sharma, Y.P. Nutritional and mineral composition of four wild edible mushrooms from Jammu and Kashmir, India. Indian Phytopathol. 2020, 73, 313–320. [Google Scholar] [CrossRef]
- Gürsoy, N.; Sarikurkcu, C.; Cengiz, M.; Solak, M.H. Antioxidant activities, metal contents, total phenolics and flavonoids of seven Morchella species. Food Chem. Toxicol. 2009, 47, 2381–2388. [Google Scholar] [CrossRef]
- Ooi, V.E.; Liu, F. Immunomodulation and anti-cancer activity of polysaccharide protein complexes. Curr. Med. Chem. 2000, 7, 715–729. [Google Scholar] [CrossRef]
- Du, X.; Zhao, Q.; Yang, Z.L. A review on research advances, issues, and perspectives of morels. Mycology 2015, 6, 78–85. [Google Scholar] [CrossRef]
- Tietel, Z.; Masaphy, S. True morels (Morchella)—nutritional and phytochemical composition, health benefits and flavor: A review. Crit. Rev. Food Sci. Nutr. 2018, 58, 1888–1901. [Google Scholar] [CrossRef]
- Akyüz, M.; Kireççi, A.D.O.; Gökce, Z.; Kirbag, S.; Yılmaz, O. Biochemical constituents and antioxidant activities of some mushrooms from Turkey: Agaricus spp., Pleurotus spp., Morchella esculenta and Terfezia boudieri. Istanb. J. Pharm. 2019, 49, 1–7. [Google Scholar]
- Li, Y.; Li, T.; Liu, R.H. Perspectives of b-glucans for health promotion. Nov. Approaches Drug Des. Dev. 2020, 5, 58–62. [Google Scholar] [CrossRef]
- Zhang, Z.; Shi, M.; Zheng, H.; Ren, R.; Zhang, S.; Ma, X. Structural characterization and biological activities of a new polysaccharide isolated from Morchella Sextelata. Glycoconj. J. 2022, 39, 369–380. [Google Scholar] [CrossRef] [PubMed]
- Taşkin, H.; Süfer, Ö.; Attar, S.H.; Bozok, F.; Baktemur, G.; Büyükalaca, S.; Kafkas, N.E. Total phenolics, antioxidant activities and fatty acid profiles of six Morchella species. J. Food Sci. Technol. 2021, 58, 692–700. [Google Scholar] [CrossRef]
- Chen, Q.; Che, C.; Yang, S.; Ding, P.; Si, M.; Yang, G. Anti-inflammatory effects of extracellular vesicles from Morchella on LPS-stimulated RAW2647 cells via the ROS-mediated p38 MAPK signaling pathway. Mol. Cell Biochem. 2022, 478, 317–327. [Google Scholar] [CrossRef] [PubMed]
- Li, F.; Wang, K.; Dong, X.; Xu, H. Structure, conformation and immunomodulatory activity of a polysaccharide from Morchella sextelata. Int. J. Food Sci. Technol. 2022, 57, 4628–4637. [Google Scholar] [CrossRef]
- Xiong, C.; Li, Q.; Chen, C.; Chen, Z.; Huang, W. Neuroprotective effect of crude polysaccharide isolated from the fruiting bodies of Morchella importuna against H2O2-induced PCl2 cell cytotoxicity by reducing oxidative stress. Biomed. Pharmacother. 2016, 83, 569–576. [Google Scholar] [CrossRef] [PubMed]
- Nitha, B.; Fijesh, P.V.; Janardhanan, K.K. Hepatoprotective activity of cultured mycelium of morel mushroom, Morchella esculenta. Exp. Toxicol. Pathol. 2013, 65, 105–112. [Google Scholar] [CrossRef]
- Öztürk, M.; Soylu, M.K.; Temel, M.; Pezikoğlu, F.; Mısır Bilen, G. Turkey’s Place in the World Mushroom Foreign Trade. IJAAES Internat. J. Anatolia Agricul. Eng. 2019, 1, 102–107. Available online: https://dergipark.org.tr/tr/pub/uazimder/issue/51011/666017 (accessed on 2 September 2024).
- Du, X.H.; Zhao, Q.; Yang, Z.L. Diversity, evolutionary history and cultivation of morels: A review. Mycosystema 2014, 33, 183–197. [Google Scholar]
- Kuo, M.; Dewsbury, D.R.; O’Donnell, K.; Carter, M.C.; Rehner, S.A.; Moore, J.D.; Moncalvo, J.M.; Canfield, S.A.; Stephenson, S.L.; Methven, A.S.; et al. Taxonomic revision of true morels (Morchella) in Canada and the United States. Mycologia 2012, 104, 1159–1177. [Google Scholar] [CrossRef]
- Mortimer, P.E.; Karunarathna, S.C.; Li, Q.H.; Gui, H.; Yang, X.Q.; Yang, X.F.; He, J.; Ye, L.; Guo, J.Y.; Li, H.L.; et al. Prized edible Asian mushrooms: Ecology, conservation and sustainability. Fungal Divers. 2012, 56, 31–47. [Google Scholar] [CrossRef]
- Richard, F.; Bellanger, J.M.; Clowez, P.; Hansen, K.; O’Donnell, K.; Urban, A.; Sauve, M.; Courtecuisse, R.; Moreau, P.A. True morels (Morchella, Pezizales) of Europe and North America: Evolutionary relationships inferred from multilocus data and a unified taxonomy. Mycologia 2015, 107, 359–382. [Google Scholar] [CrossRef] [PubMed]
- Taylor, J.W.; Jacobsen, D.J.; Kroken, S.; Kasuga, T.; Geiser, D.M.; Hibbett, D.S.; Fisher, M.C. Phylogenetic species recognition and species concepts in fungi. Fungal Genet. Biol. 2000, 31, 21–32. [Google Scholar] [CrossRef] [PubMed]
- Taskin, H.; Büyükalaca, S.; Doğan, H.H.; Rehner, S.A.; O’Donnell, K. A multigene molecular phylogenetic assessment of true morels (Morchella) in Turkey. Fungal Genet. Biol. 2010, 47, 672–682. [Google Scholar] [CrossRef]
- Taşkın, H.; Büyükalaca, S.; Hansen, K.; O’Donnell, K. Multilocus phylogenetic analysis of true morels (Morchella) reveals high levels of endemics in Turkey relative to other regions of Europe. Mycologia 2012, 104, 446–461. [Google Scholar] [CrossRef]
- O’Donnell, K.; Rooney, A.P.; Mills, G.L.; Kuo, M.; Weber, N.S.; Rehner, S.A. Phylogeny and historical biogeography of true morels (Morchella) reveals an early Cretaceous origin and high continental endemism and provincialism in the Holarctic. Fungal Genet. Biol. 2011, 48, 252–265. [Google Scholar] [CrossRef] [PubMed]
- Du, X.H.; Zhao, Q.; O’Donnell, K.; Rooney, A.P.; Yang, Z.L. Multigene molecular phylogenetics reveals true morels (Morchella) are especially species-rich in China. Fungal Genet. Biol. 2012, 49, 455–469. [Google Scholar] [CrossRef]
- Zeng, N.K.; Tang, L.P.; Li, Y.C.; Tolgor, B.; Zhu, X.T.; Zhao, Q.; Yang, Z.L. The genus Phylloporus (Boletaceae, Boletales) from China: Morphological and multilocus DNA sequence analyses. Fungal Divers. 2013, 58, 73–101. [Google Scholar] [CrossRef]
- Elliott, T.F.; Bougher, N.L.; O’Donnell, K.; Trappe, J.M. Morchella australiana sp. nov., an apparent Australian endemic from New South Wales and Victoria. Mycologia 2014, 106, 113–118. [Google Scholar] [CrossRef] [PubMed]
- Pildain, M.B.; Visnavsky, S.B.; Barroetave~na, C. Phylogenetic diversity of true morels (Morchella), the main edible non-timber product from native Patagonian forests of Argentina. Fungal Biol. 2014, 118, 755–763. [Google Scholar] [CrossRef]
- Voitk, A.; Burzynski, M.; O’Donnell, K.; Voitk, M.; Marceau, A. Mel-36-preliminary description of a new morel species. Omphalina 2014, 5, 7–10. [Google Scholar]
- Sesli, E.; Denchev, C.M. Checklists of the myxomycetous, larger ascomycetes, and larger basidiomycetes in Turkey, 6th ed. Mycotaxon 2014, 1–136. Available online: http://www.mycotaxon.com/resources/checklists/sesli-v106-checklist.pdf (accessed on 2 September 2024).
- Solak, M.H.; Işıloğlu, M.; Kalmış, E.; Allı, H. Macrofungi of Turkey, Checklist; Üniversiteliler Ofset: İzmir, Turkey, 2015; Volume 2. [Google Scholar]
- Keskinkılıç, İ. Contribution to Genetic Diversıty of Morchella (morel) Genus in Türkiye Using Molecular Methods. Master’s Thesis, Department of Biotechnology, Instıtute of Natural and Applied Sciences, University of Çukurova, Adana, Turkey, 2019; 71p. [Google Scholar]
- Işıloğlu, M.; Allı, H.; Spooner, B.M.; Solak, M.H. Morchella anatolica (Ascomycota), a new species from southwestern Anatolia, Turkey. Mycologia 2010, 102, 455–458. [Google Scholar] [CrossRef]
- Taşkın, H.; Doğan, H.H.; Büyükalaca, S.; Clowez, P.; Arthur, P.A.; O’Donnell, K. Four new morel (Morchella) species in the Elata Subclade (sect. Distantes) from Turkey. Mycotaxon 2016, 131, 467–482. [Google Scholar] [CrossRef]
- Liu, Q.; Ma, H.; Zhang, Y.; Dong, C. Artificial cultivation of true morels: Current state, issues and perspective. Crit. Rev. Biotechnol. 2017, 38, 259–271. [Google Scholar] [CrossRef]
- Xu, Y.; Tang, J.; Wang, Y.; He, X.; Tan, H.; Yu, Y.; Chen, Y.; Peng, W. Large-scale commercial cultivation of morels: Current state and perspectives. Appl. Microbiol. Biotechnol. 2022, 106, 4401–4412. [Google Scholar] [CrossRef]
- Ge, S. Studies on Molecular Identification, Biological Characteristics and Indoor Cultivation of Morchella spp. Master’s Thesis, Department of Plant Pathology and Environmental Microbiology of the Pennsylvania State University, University Park, PA, USA, 2019; 166p. [Google Scholar]
- Anonymous. Forest Fire Statistics of General Directorate of Forestry of Agriculture and Forestry Ministry of Republic of Türkiye. 2021. Available online: https://www.ogm.gov.tr/tr/e-kutuphane-sitesi/Istatistikler/Ormanc%C4%B1l%C4%B1k%20%C4%B0statistikleri/Ormanc%C4%B1l%C4%B1k%20%C4%B0statistikleri%202021.zip (accessed on 2 September 2024).
- Chang, S.T.; Miles, P.G. Mushrooms: Cultivation, Nutritional Value, Medicinal Effect, and Environmental Impact, 2nd ed.; CRC Press: Boca Raton, FL, USA, 2004. [Google Scholar]
- Nakasone, K.K.; Peterson, S.W.; Jong, S.C. Preservation and distribution of fungal cultures. In Biodiversity of Fungi: Inventory and Monitoring Methods; Elsevier: Amsterdam, The Netherlands; Academic Press: Cambridge, CA, USA, 2004; pp. 37–47. [Google Scholar]
- White, T.J.; Bruns, T.; Lee, S.; Taylor, J. Amplification and Direct Sequencing of Fungal Ribosomal RNA Genes for Phylogenetics; Academic Press: Cambridge, CA, USA, 1990; pp. 315–322. [Google Scholar]
- Masaphy, S. Biotechnology of morel mushrooms: Successful fruiting body formation and development in a soilless system. Biotechnol. Lett. 2010, 32, 1523–1527. [Google Scholar] [CrossRef]
- Zhao, Q.; Xu, Z.Z.; Cheng, Y.H.; Qi, S.W.; Hou, Z.J. Bionic cultivation of Morchella conica. Southwest China J. Agric. Sci. 2009, 22, 1690–1693. [Google Scholar]
- Zhao, Q.; Lv, M.; Li, L.; Huang, W.; Zhang, Y.; Hao, Z. “Temptation” and “Trap” of Morel industry in China. J. Fungal Res. 2021, 19, 232–237. [Google Scholar] [CrossRef]
- Sesli, E.; Asan, A.; Selçuk, F.; Akata, I.; Akgül, H.; Aktaş, S.; Allı, H.; Demirel, K.; Doğan, H.H.; Kaya, A.; et al. Türkiye Mantarları Listesi. Ali Nihat Gökyiğit Vakfi Yayin. İstanbul 2020, 1177. [Google Scholar]
- Solak, M.H.; Türkoğlu, A. Macrofungi of Turkey (Checklist Volume III); Kanyılmaz Matbaacılık, Bornova-İZMİR: İzmir, Turkey, 2022. [Google Scholar]
- Loizides, M.; Alvarado, P.; Clowez, P.; Moreau, P.A.; Romero de la Osa, L.; Palazón, A. Morchella tridentina, M. rufobrunnea, and M.kakiicolor: A study of three poorly known Mediterranean morels, with nomenclatural updates in section Distantes. Mycol. Prog. 2015, 14, 13. [Google Scholar] [CrossRef]
- Miller, A.N.; Raudabaugh, D.B.; Iturriaga, T.; Matheny, P.B.; Petersen, R.H.; Hughes, K.W.; Gube, M.; Powers, R.A.; James, T.Y.; O’donnell, K. First report of the post-fire morel Morchella exuberans in eastern North America. Mycologia 2017, 109, 710–714. [Google Scholar] [CrossRef]
- Hobbie, E.A.; Rice, S.F.; Weber, N.S.; Smith, J.E. Isotopic evidence indicates saprotrophy in post-fire Morchella in Oregon and Alaska. Mycologia 2016, 108, 638–645. [Google Scholar] [CrossRef]
- Pilz, D.; Rebecca, M.L.; Susan, A.; Villarreal-Ruiz, L.; Berch, S.; Wurtz, T.L.; Parks, C.G.; McFarlane, E.; Baker, B.; Molina, R. Ecology and Management of Morels Harvested from the Forests of Western North America; US Department of Agriculture, Forest Service, Pacific Northwest Research Station: Portland, OR, USA, 2007. [CrossRef]
- Kalmis, E.; Kalyoncu, F. Mycelial growth rate of some morels (Morchella spp.) in four different microbiological media. Am. Eurasian J. Agric. Environ. Sci. 2008, 3, 861–864. [Google Scholar]
- He, P.; Cai, Y.; Liu, S.; Han, L.; Huang, L.; Liu, W. Morphological and ultrastructural examination of senescence in Morchella elata. Micron 2015, 78, 79–84. [Google Scholar] [CrossRef]
- He, P.; Liu, W.; Cai, Y.; Ma, B.; Chen, L.; Wu, X. Effects of oxidative stress on mycelial growth and sclerotial metamorphosis of Morchella crassipes. Hubei Agric. Sci. 2014, 53, 3085–3089. [Google Scholar]
- Güler, P.; Özkaya, E.G. Morphological development of Morchella conica mycelium on different agar media. J. Environ. Biol. 2009, 30, 601–604. [Google Scholar]
- Rollins, J.A.; Dickman, M.B. Increase in endogenous and exogenous cyclic AMP levels inhibits sclerotial development in Sclerotinia sclerotiorum. Appl. Environ. Microbiol. Biotechnol 1998, 64, 2539–2544. [Google Scholar] [CrossRef]
- Wang, D.; Fu, J.; Zhou, R.; Li, Z.; Xie, Y.; Liu, X.; Han, Y. Formation of sclerotia in Sclerotinia ginseng and composition of the sclerotial exudate. PeerJ 2018, 6, e6009. [Google Scholar] [CrossRef] [PubMed] [PubMed Central]
- Liang, Y.; Strelkov, S.E.; Kav, N.N.V. The proteome of liquid Sclerotial exudates from Sclerotinia sclerotiorum. J. Proteome Res. 2010, 9, 3290–3298. [Google Scholar] [CrossRef] [PubMed]
- Willetts, H.J. The survival of fungal sclerotia under adverse environmental conditions. Biol. Rev. 1971, 46, 387–407. [Google Scholar] [CrossRef]
- Sanz-Rocha, M.; Gerding, M.; Quezada, T.; Vargas, M.; Chávez, D.; Machuca, Á. Molecular and cultural characterization of Morchella spp. from disturbed environments of central-southern Chile. Fungal Biol. 2023, 127, 938–948. [Google Scholar] [CrossRef] [PubMed]
- Kalyoncu, F.; Oskay, M.; Kalyoncu, M. The effects of some environmental parameters on mycelial growth of six Morchella species. J. Pure Appl. Microbiol. 2009, 3, 467–472. [Google Scholar]
- Amir, R.; Levanon, D.; Hadar, Y.; Chet, I. Morphology and physiology of Morchella esculenta during sclerotial formation. Mycol. Res. 1993, 97, 683–689. [Google Scholar] [CrossRef]
- Kanwal, N.; William, K.; Sultana, K. In vitro propagation of Morchella esculenta and study of its life cycle. J. Bioresour. Manag. 2016, 3, 6. [Google Scholar]
- Liu, W.; He, P.; Zhang, J.; Wu, L.; Er, L.; Shi, X.; Gu, Z.; Yu, F.; Pérez-Moreno, J. Ultrastructure and physiological characterization of Morchella mitospores and their relevance in the understanding of the morel life cycle. Microorganisms 2023, 11, 345. [Google Scholar] [CrossRef]

| Species | Accession and İsolate No | Origin | Dominant Plant | GPS Coordinates |
|---|---|---|---|---|
| M. crassipes | 962-Kg115 | Bursa-İnegöl-Kurşunlu | Populus sp. | 40°00′044″ N-29°40′041″ E-487 m |
| 1012-Kg250 | Ankara-Nallıhan | Fired Pine forest | 40°06′054″ N-30°53′008″ E-369 m | |
| 956-Kg106 | Bursa-İnegöl-Close to quarry mine | Mix Populus-Quercus | 40°01′074″ N-29°37′908″ E | |
| 972-Kg176 | Manisa-Akhisar-Yayakırıldık | Fired Pine forest | 38°52′181″ N-028°04′325″ E-328 m | |
| 1013-Kg254 | Ankara-Nallıhan | Fired Pine forest | 40°11′051″ N-31°27′025″ E-805 m | |
| 1014-Kg257 | Ankara-Nallıhan | Fired Pine forest | 40°11′051″ N-31°27′057″ E-827 m | |
| M. esculenta | 961-Kg116 | Bursa-İnegöl-Cerrah | Populus sp. | 40°04′563″ N-029°27′711″ E-308 m |
| M. vulgarius/ M. spongiola | 976-Kg187 | Manisa-Osmancalı | Fired Pine forest | 38°47′028″ N-27°161′86″ E-341 m |
| M. tridentina | 967-Kg146 | Çanakkale-Bayramiç-Kaykılar | Pinus sp. | 39°50′031″ N-26°44′015E-389 m |
| 951-Kg038 | İzmir-Mordoğan | Strawberry greenhouse | 38°30491″ N-26°36′54″ E-77 m | |
| 955-Kg089 | Bursa-İnegöl-Çitli | Populus sp. | 40°01.072 N-29°37.140 E-373 m | |
| 957-Kg108 | Bursa-İnegöl-Çitli | Populus sp. | 40°01′072″N-29°37′140″ E-373 m | |
| 965-Kg136 | Çanakkale-Bayramiç | Pinus sp. | 39°45′051″ N-26°37′008″ E-262 m | |
| 974-Kg178 | Manisa-Salihli-İğdecik | Quercus sp. | 38°34′321″ N-028°22′525″ E-616 m | |
| 848-Kg137 | İzmir-Bergama-Göbeller | Pinus pinea | 39°242′67 80″ N-27°025′39 30″ E | |
| M. exuberans | 963-Kg121 | Bilecik-Osmaneli-Dereyörük | Fired Pine forest | 40°18.051 N-29°51.025 E-269 m |
| M. exima | 851-Kg016 | İzmir-Balçova | Pinus sp. | 38°22′042″ N-27°02′037″ E-320 m |
| 969-Kg161 | Muğla-Köyceğiz | Pinus sp. | 37°00′052″ N-28°42′026″ E-469 m | |
| 856-Kg026 | Kastamonu-Taşköprü-Aslanlı | Fired Pine-poplar forest | 41°328′7600″ N-34°52′6970″ E | |
| 1017-Kg266 | Ankara-Nallıhan | Fired Pine forest | 40°15′055″ N-31°31′003″ E-1154 m | |
| 855-Kg001 | Kastamonu-Taşköprü-Dedeağaç-Duman | Fired Pine forest | 41°358′27 60″ N-34°190′6300″ E | |
| M. sponigoal/ M. vulgaris | 976-Kg187 | Manisa-Osmancalı | Fired Pine forest | 38°47′028″ N-27°161′86″ E-341 m |
| M. importuna | 978-Kg189 | Muğla-Milas | Fruit orchard | 37°13′005″ N-28°28′007″ E-1353 m |
| 977-Kg188 | Bursa-İnegöl | Fruit orchard | 39°59′045″ N-29°41′035″ E-936 m | |
| 968-Kg152 | Çanakkale-Bayramiç-Hacıköy | Fired Pine forest | 39°53′029″ N-26°37′002″ E-205 m | |
| 846-Kg010 | Yalova-Çınarcık | Tilia sp. Waste of black tea | 40°38′043″ N-29°07′011″ E-17 m | |
| 971-Kg167 | Manisa-Akhisar-Yayakırıldık | Fired Pine forest | 38°52′181″ K-028°04′325″ D-328 m | |
| 975-Kg181 | Manisa-Osmancalı | Fired Pine forest | 38°47′028″ N-027°161′86″ E-341 m | |
| 852-Kg005 | Manisa-Muradiye | Fired Pine forest | 38°715′4420″ N-27°25′15720″ E | |
| 852-Kg008 | Manisa-Muradiye | Fired Pine forest | 38°715′4420″ N-27°25′15720″ E | |
| 970-Kg164 | Çanakkale-Merkez-Kızılkeçili | Pinus sp. | 40°11′040″ N-26°34′029″ E-219 m | |
| 964-Kg133 | Bilecik-Osmaneli-Dereyörük | Fired Pine forest | 40°18′050″ N-29°51′024″ E-274 m | |
| 845-Kg019 | Yalova-Çınarcık | Tilia sp. Waste of black tea | 40°38′041″ N-29°07′007″ E-21 m | |
| 949-Kg030 | İzmir-Tırazlı-Karabağlar | Pinus sp. | 38°21′484″ N-27°03′101″ E | |
| 952-Kg040 | İzmir-Menderes-Çile | Fired pine forest | 38°02′308″ N-27°10′796″ E-163 m | |
| 973-Kg177 | Manisa-Akhisar-Yayakırıldık | Fired Pine forest | 38°52′180″ K-028°04′326″ D-330 m | |
| Unidentified | 849-Kg027 | İzmir-Bergama | Pinus pinea | 39°242′6780″ N-27°025′3930″ E |
| 966-Kg142 | Çanakkale-Bayramiç-Kaykılar | Pinus sp. | 39°50′016″ N-26°43′053″ E-327 m | |
| M. dunali | 953-Kg054 | İzmir-Menderes-Çile | Pinus sp. | 38°01′664″ N-27°09′474″ E-325 m |
| 954-Kg071 | İzmir-Menderes-Karacadağ | Pinus sp. | 38°05′151″ N-27°07′785″ E-507 m | |
| M. esculenta | M10110 | Belgium-Mycelia company | Commercial strain | |
| 8# | China | Commercial strain | ||
| M. importuna | 3 mix | China | Commercial strain |
Disclaimer/Publisher’s Note: The statements, opinions and data contained in all publications are solely those of the individual author(s) and contributor(s) and not of MDPI and/or the editor(s). MDPI and/or the editor(s) disclaim responsibility for any injury to people or property resulting from any ideas, methods, instructions or products referred to in the content. |
© 2024 by the author. Licensee MDPI, Basel, Switzerland. This article is an open access article distributed under the terms and conditions of the Creative Commons Attribution (CC BY) license (https://creativecommons.org/licenses/by/4.0/).
Share and Cite
Soylu, M.K. Isolation and Molecular Identification of the Pure Culture of Morchella Collected from Türkiye and Its Characteristics. Horticulturae 2024, 10, 1020. https://doi.org/10.3390/horticulturae10101020
Soylu MK. Isolation and Molecular Identification of the Pure Culture of Morchella Collected from Türkiye and Its Characteristics. Horticulturae. 2024; 10(10):1020. https://doi.org/10.3390/horticulturae10101020
Chicago/Turabian StyleSoylu, Mustafa Kemal. 2024. "Isolation and Molecular Identification of the Pure Culture of Morchella Collected from Türkiye and Its Characteristics" Horticulturae 10, no. 10: 1020. https://doi.org/10.3390/horticulturae10101020
APA StyleSoylu, M. K. (2024). Isolation and Molecular Identification of the Pure Culture of Morchella Collected from Türkiye and Its Characteristics. Horticulturae, 10(10), 1020. https://doi.org/10.3390/horticulturae10101020
